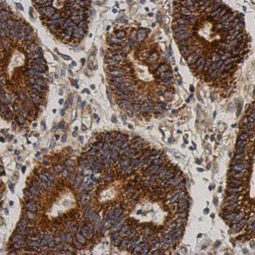

Neuroscience research has become a major focus for countries all over the world. The United States, European nations, Japan, China, India, and other countries have initiated, or plan to initiate, ambitious brain and neuroscience programs. In the United States, for example, the White House BRAIN Initiative, unveiled by President Obama in 2013, draws support from five federal agencies to drive advances in basic neuroscience research, cognition, traumatic brain injury, and neuropsychiatry, among other fields. Similar efforts from other nations will likely complement or expand this vision, making neuroscience research a top priority for the world scientific community.
Neuroscience


Neural stem cells (NSCs) are self-renewing multipotent populations present in the developing and adult mammalian CNS. NSCs develop from the ectoderm-derived neural crest in vivo, or can be experimentally derived or induced from different sources in vitro. NSC can generate the neurons and glia in the brain. These neurons and glia express unique sets of adhesion molecules, cytoskeletal proteins, transcription factors, and surface receptors.
GeneTex is proud to offer an outstanding selection of antibody reagents for neuroscience research, featuring antibodies against unique cell type markers for detection of neurons, glia and microglia. Please see the highlighted antibodies below.
| Neural Progenitor Cell Markers | |||||
|
|
|||||
| Immature Neuron Markers | |||||
|
|
|||||
| Mature Neuron Markers | |||||
|
|
|||||


The retina is a light-sensitive layer of tissue on the back of the eye situated around the optic nerve. Light focused by the lens onto the retina initiates a cascade of signals that are relayed to the brain via the optic nerve to allow visual perception. Structurally, the retina consists of three layers of nerve cell bodies (including photoreceptor cells, bipolar cells, amacrine cells, horizontal cells, and ganglion cells), two layers of synapses, and the layer of pigmented epithelial cells.
GeneTex is proud to offer an outstanding selection of antibodies for vision and retina research. We offer reliable IHC-validated and/or ICC/IF-validated antibodies to facilitate your research efforts in this exciting field. Please see the highlighted antibodies below.


OTX2 antibody
|


PKC alpha antibody
(GTX130453)
![]()
![]()
![]()
![]()
![]()
![]()
![]()
![]()
![]()
![]()
![]()
![]()
![]()
![]()
![]()
![]()


SCGN antibody
(GTX115443)


GFAP antibody
|


Neurites are projections from the neuronal cell body that develop into axons and dendrites to form complex neuronal circuits. These circuits are highly dynamic, with ongoing reconfiguration and refinement characteristic of the structural plasticity necessary for learning and memory. Neurite outgrowth also occurs during nerve regeneration. Chemical synapse communication is defined by the release of neurotransmitters from the pre-synaptic neuron with binding to receptors on the post-synaptic neuron. Synaptic degeneration is evident in the course of neurodegenerative disease, though the underlying mechanisms are poorly understood. To facilitate study of neurite and synapse biology, antibodies detecting neuron-specific and pre- and postsynaptic markers are essential tools for neuroscience researchers.
| Highlighted Products | |||||
|
|
|||||


Neurotransmission is the process in which a neurochemical signal is transmitted from one neuron to an adjacent neuron. Neurotransmitters are released by the presynaptic neuron, travel across the synaptic cleft, and then bind to and activate receptors on the postsynaptic neuron. There are many different types of neurotransmitters, including acetylcholine, amino acids (asparagine, GABA, glutamate, and glycine), monoamines (dopamine, histamine, epinephrine, and norepinephrine), trace amines, purines and a variety of neuropeptides.
GeneTex offers an outstanding selection of antibodies to support neurotransmission research, including reagents to study key neurotransmitters, receptors, transporters, and biosynthesis/degradation enzymes. Please see the highlighted antibodies below.
| Highlighted Products | |||||
|
|
|||||
Acetylcholine (ACh)


AChE antibody (GTX101648) |


Choline Acetyltransferase antibody (GTX113164) |


Vesicular Acetylcholine Transporter antibody (GTX133251) |
Asparagine


NMDAR1 antibody (GTX133097) |


NMDAR2A antibody (GTX103558)


NMDAR2B (phospho Tyr1472) antibody (GTX130183) |
Jeffrey C. Hall, Michael Rosbash and Michael W. Young won the 2017 Nobel Prize in Physiology or Medicine for their work identifying the mechanistic basis for the circadian rhythm in fruit flies. Circadian rhythms are physical, behavioral, and mental changes that respond primarily to the light and darkness cycle in an organism’s environment. They are found in most living things, including animals, plants, and many microbes. The study of these cyclic, physiological rhythms is generally termed chronobiology (1).
The protein factors constituting the components of this circadian clock are found in almost all of the body’s organ systems (1). The primary mammalian circadian clock is located in the suprachiasmatic nuclei in the hypothalamus. The molecular mechanism for the oscillation of the circadian rhythm involves a transcription-translation feedback loop of clock genes expressed by almost all cells. In particular, BMAL1, CLOCK, PERs, and CRYs play central roles in the oscillation of the circadian rhythm and rhythmically regulate downstream gene expression (Fig. 1). Disruption of the circadian rhythm and polymorphisms in circadian rhythm-related genes are associated with various disorders, such as neurodegeneration, infertility, and sleep disturbance (Table 1) (1).
Fig. 1. BMAL1 and CLOCK form a heterodimer that binds to the regulatory region (E-box) of Per1/2 and Cry1/2 to positively regulate transcription. PER and CRY proteins then form a complex and negatively regulate the transcriptional effects of BMAL1 and CLOCK.
Highlighted Products
![]()
![]()
![]()
![]()
![]()
![]()
![]()
![]()
![]()
![]()
![]()
![]()
![]()


CLOCK antibody (GTX134464) |


Timeless antibody (GTX129604) |


ROR alpha antibody [C3], C-term (GTX108201)
Table 1
| Disrupted gene | Physiological effects |
| Bmal1 | Infertility, Progressive arthropathy, Abnormal gluconeogenesis, Abnormal lipogenesis, Altered sleep pattern. |
| Clocka | Metabolic syndrome, Abnormal gluconeogenesis, Abnormal behavioral sensitization to psychostimulants, Altered sleep pattern. |
| Per1 | Abnormal apoptosis/cancer development, Abnormal behavioral sensitization to psychostimulants. |
| Per2 | Improper cell division/cancer development, Abnormal behavioral sensitization to psychostimulants, Improper alcohol intake, FASPS. |
| Per3 | Associated with DSPS. |
| Cry1;Cry2 | Altered sleep pattern. |
| Rorα | Cerebellar ataxia, Abnormal bone metabolism. |
| Rorβ | Locomotor difficulties, Retinal degeneration/blindness, Male reproductive abnormality. |
| Rorγ | Lack of lymphoid organ development, Abnormal lymphocyte homeostasis. |
| NPAS2 | Altered sleep pattern, Impaired memory. |
| CK1ε/CK1δ | FASPS |
Neuroinflammation occurs within the central nervous system (CNS) as a result of infection, injury, autoimmune processes, or toxicity. Microglia, as the specialized resident macrophage cells in the CNS, play crucial roles in both the initiation and resolution of neuroinflammation. However, their impact on neurons is complex. Microglia demonstrate a phenotypic plasticity that is directly influenced by the regional brain microenvironment. Thus, the M1/M2 dichotomy labeling used to describe other macrophage activity is inadequate to reflect the true heterogeneity of the microglial population. It is known that in neurodegenerative disease the microglia may display a “disease-associated microglia signature” that involves expression of genes found in both M1 and M2 profiles. Therefore, though important for the initial response to neuronal insult, microglia often contribute to the neuronal loss characteristic of these diseases.
GeneTex is proud to offer an outstanding, well-cited Iba1 antibody (GTX101495) as an important addition to your reagent collection for microglia research. This antibody was validated in part through side-by-side comparison with other market-leading antibodies for western blot and immunohistochemistry (Fig. 1 and Fig. 2) *.


Fig. 1. Western blot of THP-1 and HL-60 whole cell extracts probed with GeneTex Iba1 antibody (GTX101495) or competitors’ antibodies.


Fig. 2. IHC analysis staining microglial cells in mouse cerebellum sections with either GeneTex Iba1 antibody (GTX101495) or competitor’s antibody.
For more antibodies to study neuroinflammation, please see the featured products below
Featured Products
| |


Neuropeptides are small polypeptides (~3-100 residues) processed from larger precursors. Unlike conventional neurotransmitters (such as GABA, dopamine and glutamate) that are stored in small synaptic vesicles, neuropeptides are generally packaged in large dense-core vesicles that can be targeted to both axons and dendrites. They are key signaling factors involved in neuromodulation through functional interaction with neurotransmitters. Neuropeptides typically exert their effects through binding to G-protein-coupled receptors (GPCRs).
GeneTex provides a selection of neuropeptide-related products, including antibodies detecting neuropeptide precursors, mature neuropeptides, and their corresponding receptors. Please see the highlighted antibodies below.
Highlighted Products
![]()
![]()
![]()
![]()
![]()
![]()
![]()


Somatostatin antibody (GTX133119) |


Somatostatin receptor 3 antibody (GTX130114) |


LHR antibody [C3], C-term (GTX100008) |


Ion channels are pore-forming, usually multimeric plasma membrane proteins that can open and close in response to chemical, temperature, or mechanical signals. An open channel allows specific ions to rapid ly traverse the transmembrane passageway a long an electrochemical gradient, generating an electrical signal that is propagated along excitable cells. Ion channels are of immense importance in clinical medicine as they are linked to a broad array of disorders and are targets of an ever-expanding, and commonly prescribed, armamentarium of pharmacologic agents. Nevertheless, there remains a great void in our understanding of ion channel biology, which limits our ability to develop more effective and mo re specific drugs.
GeneTex offers an outstanding selection of antibodies to support ion channel research.Please see the highlighted antibodies in this flyer or review our complete list of related products on the GeneTex website.


HCN1 antibody (GTX131334)
IHC-Fr (left; Green) and IHC-P (right) analysis of HCN1 expression in mouse cerebellum.


DPP6 antibody (GTX133338)
IHC-Fr (left; Green) and IHC-P (right) analysis of DPP6 expression in mouse hippocampus.


IP3 Receptor I antibody (GTX133104)
IHC-Fr (left; Green) and IHC-P (right) analysis of IP3 Receptor I expression in mouse cerebellum.


CACNB4 (GTX100202)
IHC-Fr (left; Green) and IHC-P (right) analysis of CACNB4 expression in mouse cerebellum.


VGluT1 antibody (GTX133148)
IHC-Fr (left; Green) and IHC-P (right) analysis of VGluT1 expression in mouse cerebellum.


P2X7 antibody (GTX104288)
IHC-Fr (left; Green) and IHC-P (right) analysis of P2X7 expression in mouse retina (left) and rat brain (right).


| Despite a diverse array of clinical manifestations and affected genes, many of the common neurodegenerative disorders share a similar molecular mechanism. Alzheimer’s disease (AD), Parkinson’s disease (PD), Huntington’s disease (HD), amyotrophic lateral sclerosis (ALS) and prion disease are each characterized by the aggregation of mutated or misfolded proteins into amyloid inclusion bodies. Aggregation results when the accumulation of misfolded proteins exceeds the cell’s ability to eliminate them via the ubiquitin-proteasome degradation pathway. Some evidence suggests that these inclusions may represent a cellular defense mechanism intended to sequester toxic oligomers or to induce autophagic elimination of the diseased proteins. Effective future strategies for treatment of these neurodegenerative disorders rely on the understanding of the basic pathways affected in these disorders. |
| Disease | Type of Aggregation | Subcellular | Affected Protein | Brain Region Affected |
| Alzheimer’s Disease (AD) | Neuritic Plaques | Extracellular | Amyloid beta peptide | Cortex, hippocampus, basal forebrain, brain stem |
| Neurofibrillary tangles | Intracellular | Hyperphosphorylated Tau | Neurofibrillary tangles | Intracellular |
| Parkinson’s Disease (PD) | Lewy Body | Intracellular (Cytoplasm) | α-Synuclein | Substantia nigra, cortex, locus ceruleus, rephe (dopaminergic neurons) |
| Huntington’s Disease (HD) | Intranuclear inclusions & cytoplasmic aggregates | Intracellular | Huntingtin with polyglutamate expansion | Striatum, basal ganglia, cortex, others |
| Amyotrophic Lateral Sclerosis (ALS) | Bonina bodies and axonal spheroids | Intracellular (Cytoplasm) | Various ALS genes | Spinal motor neurons and motor cortex |
GeneTex proudly offers an excellent catalog of high-quality antibodies to study the processes involved in neurodegenerative disorders, the majority of which are validated for multiple applications. Please view the table below of selected antibodies and consider whether they can help accelerate your research.


Amyotrophic lateral sclerosis (ALS) is an invariably fatal adult-onset neurodegenerative disorder characterized by the progressive loss of both upper and lower motor neurons. The major clinical presentation of ALS is muscle weakness and atrophy affecting speech, swallowing, and movement, with respiratory failure being the most common reason for death usually within 3-5 years of diagnosis. Though the cause is unknown, recent studies have identified several genes associated with the disease including SOD1, TARDBP, FUS, C9orf72, C21orf2, and most recently NEK1.
GeneTex is proud to offer exceptional antibodies against these targets relevant to ALS. Please see the examples highlighted below and the accompanying table to find the reagent that facilitates your ALS research.
Highlighted Products:
![]()
![]()
![]()
![]()
![]()
![]()
![]()
![]()